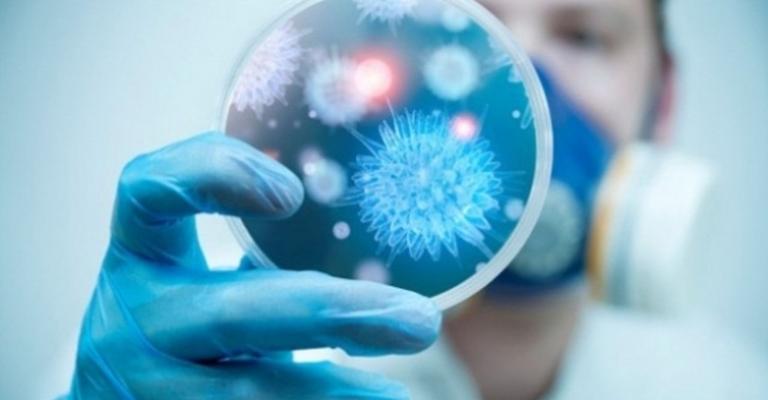
الصحة تبدأ رصد "كورونا" عند الحجاج العائدين

عمان نت


أجريت عملية جراحية نوعية للمرة الأولى في مستشفى الملك المؤسس عبدالله الجامعي والأردن، لفصل العصب الخامس في قاع الدماغ الخلفي بالمنظار لمريضة خمسينية تعاني من آلام العصب الخامس غير مستجيبة للعلاجلات

تعتزم أمانة عمّان ضمن توجه لما قالت أنه تنمية وتطوير شرق عمان إلى إنشاء الميناء البري ومدينة السيارات في منطقة الماضونة. وأضاف بيان للأمانة أن ذلك يأتي من خلال خطط وزارة النقل ودائرة الجمارك، بحيث يتم
أهابت وزارة الصحة بالحجاج العائدين من أداء مناسك الحج لهذا العام مراجعة اقرب مستشفى أو مركز صحي حال ظهور أي أعراض مرضية في الجهاز التنفسي أو ارتفاع في درجة الحرارة . وقال وزير الصحة الدكتور علي حياصات

أكّدت وزارة الأوقاف والشؤون والمقدسات الإسلامية اليوم الإثنين أن كافة الحجاج الأردنيين المسافرين برّا غادروا مكة اليوم متوجهين إلى الأراضي الأردنيّة، في حين ينتظر المسافرون منهم جواً طائراتهم للعودة

كشف وزير الأوقاف والشؤون والمقدسات الإسلاميّة هايل عبد الحفيظ الداوود عن مخاطبة الأردن لإسرائيل بشأن عودة التوتر لباحات المسجد الأقصى صباح اليوم الإثنين، والتي أدت لقوقوع الإصابات في صفوف المرابطين،
أعلنت مؤسسة عبد الحميد شومان عن فتح باب الترشيح لجائزة عبد الحميد شومان لأدب الأطفال لعام2015 بحيث يكون آخر موعد لقبول الترشيحات نهاية شهر شباط 2016. وقال بيان للمؤسسة اليوم الإثنين أن الجائزة تمنح
أعلنت أمانة عمّان اليوم الإثنين عن بدء رش وتعقيم أماكن بيع وذبح الأضاحي، بعد قيامها بجرف هذه المواقع أمس الأحد وإزالة المخلفات فيها بعد أن تم إخلائها. وقال المدير التنفيذي للأسواق في الأمانة عبد

صدر عن المؤسسة العربية للدراسات والنشر رواية جديدة للكاتبة سلوى جراح بعنوان "أبواب ضيقة" حيث قدم مراجعة للرواية الدكتور برهان شاوي. ويقول الشاوي في الرواية "حين انتهيت من قرائتها تذكرت ما كتبته وقلته
قال الأمن العام اليوم الإثنين أن سير التحقيق بحادثة استشهاد الوكيل خالد بني مفرج من مرتب إدارة البحث الجنائي تعرض "لعرقلة" مضيفاً أنه بالإضافة إلى ذلك تعرض الرأي العام للتشويش من جهة ودفع الفاعل نحو












































